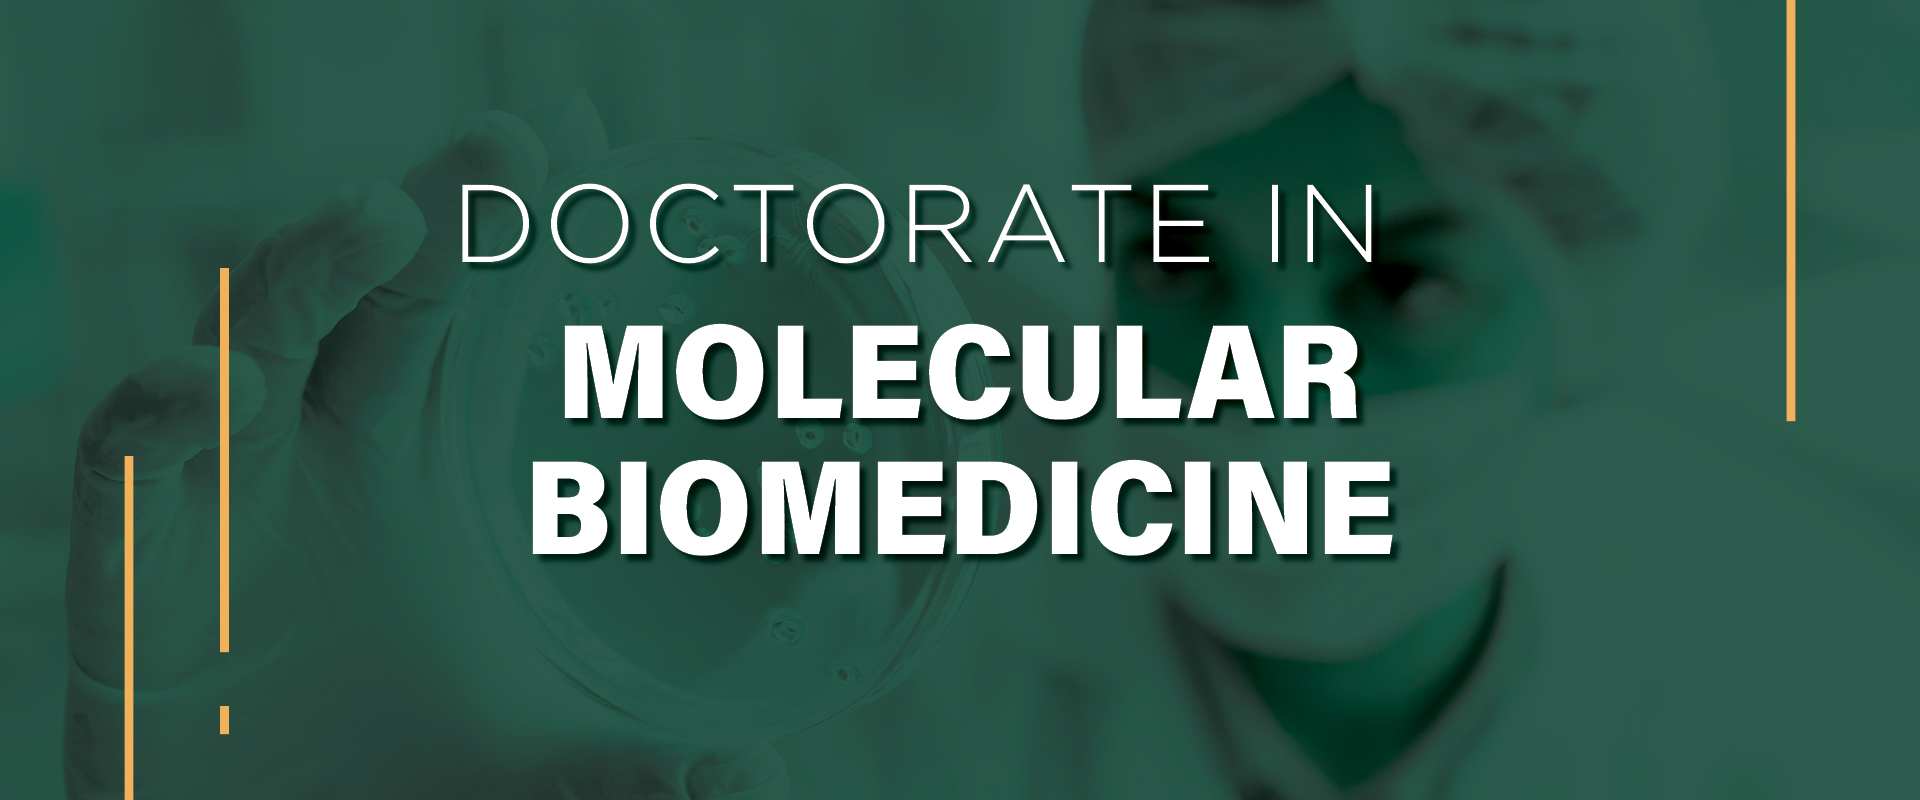
Molecular Biomedicine *

Molecular Biomedicine
Biomedical research is of great relevance at the level of transnational research worldwide, and Mexico is no exception. The discovery, development, and validation of chemical compounds with biological activity or therapeutic potential are key to biomedical research. The Doctorate in Molecular Biomedicine at UDLAP aims to train postgraduates in molecular biomedicine, capable of designing and developing collaborative and cutting-edge research integrating different disciplines from medical and chemical-biological areas with complementary approaches; as well as mastering molecular biomedicine technologies, techniques, and laboratory equipment in biomedical research through the development of biological, biotechnological, and chemical products to solve health problems, enhance biomedical research, and contribute to the quality of life of the population.
Study
Plan
Molecular BiomedicineFirst Term |
|||||
|---|---|---|---|---|---|
| Course List | Code | Sequence | Hours | Credits (Units) | |
| With Teacher | Independent | ||||
| DESIGN OF EXPERIMENTS AND BIOSTATISTICS | DBM5011 | 48 | 48 | 6 | |
| EXPERIMENTAL ANALYTICAL METHODS | DBM5031 | 48 | 48 | 6 | |
| MOLECULAR AND CELLULAR BIOLOGY | DBM5021 | 48 | 48 | 6 | |
| PHARMACOLOGY AND TOXICOLOGY | DBM5041 | 48 | 48 | 6 | |
| 192 | 192 | 24 | |||
Molecular BiomedicineSecond Term |
|||||
|---|---|---|---|---|---|
| Course List | Code | Sequence | Hours | Credits (Units) | |
| With Teacher | Independent | ||||
| *BASIC ELECTIVE 1 | 48 | 48 | 6 | ||
| EXPERIMENTAL BIOLOGICAL AND MOLECULAR METHODS | DBM5071 | 48 | 48 | 6 | |
| MEDICINAL DRUG DESIGN | DBM5061 | 48 | 48 | 6 | |
| PHYSIOPATHOLOGY | DBM5051 | 48 | 48 | 6 | |
| 192 | 192 | 24 | |||
*Remite a ELECTIVAS para elegir una asignatura
Molecular BiomedicineThird Term |
|||||
|---|---|---|---|---|---|
| Course List | Code | Sequence | Hours | Credits (Units) | |
| With Teacher | Independent | ||||
| *BASIC ELECTIVE 2 | 48 | 48 | 6 | ||
| COMPREHENSIVE EXAM * | DBM7121 |
DBM5011 DBM5021 DBM5031 DBM5041 DBM5051 DBM5061 DBM5071 |
16 | 16 | 2 |
| PROFESSIONAL RESPONSIBILITY SEMINAR * | PTA5011 | 48 | 48 | 6 | |
| THESIS I * | DBM5161 |
DBM5011 DBM5021 DBM5031 DBM5041 DBM5051 DBM5061 DBM5071 |
48 | 48 | 6 |
| 160 | 160 | 20 | |||
*Remite a ELECTIVAS para elegir una asignatura
*Para cursar la asignatura COMPREHENSIVE EXAM (Clave: DBM7121) es necesario haber acreditado previamente
- DESIGN OF EXPERIMENTS AND BIOSTATISTICS
- MOLECULAR AND CELLULAR BIOLOGY
- EXPERIMENTAL ANALYTICAL METHODS
- PHARMACOLOGY AND TOXICOLOGY
- PHYSIOPATHOLOGY
- MEDICINAL DRUG DESIGN
- EXPERIMENTAL BIOLOGICAL AND MOLECULAR METHODS
*Para cursar la asignatura THESIS I (Clave: DBM5161) es necesario haber acreditado previamente
- DESIGN OF EXPERIMENTS AND BIOSTATISTICS
- MOLECULAR AND CELLULAR BIOLOGY
- EXPERIMENTAL ANALYTICAL METHODS
- PHARMACOLOGY AND TOXICOLOGY
- PHYSIOPATHOLOGY
- MEDICINAL DRUG DESIGN
- EXPERIMENTAL BIOLOGICAL AND MOLECULAR METHODS
Molecular BiomedicineFourth Term |
|||||
|---|---|---|---|---|---|
| Course List | Code | Sequence | Hours | Credits (Units) | |
| With Teacher | Independent | ||||
| BIOETHICS | DBM5221 | 16 | 0 | 1 | |
| PRE-DOCTORAL EXAM * | DBM7131 |
DBM7121 |
16 | 16 | 2 |
| THESIS II * | DBM5171 |
DBM5161 |
48 | 48 | 6 |
| 80 | 64 | 9 | |||
*Para cursar la asignatura PRE-DOCTORAL EXAM (Clave: DBM7131) es necesario haber acreditado previamente
- COMPREHENSIVE EXAM
*Para cursar la asignatura THESIS II (Clave: DBM5171) es necesario haber acreditado previamente
- THESIS I
*Remite a ELECTIVAS para elegir una asignatura
Molecular BiomedicineSixth Term |
|||||
|---|---|---|---|---|---|
| Course List | Code | Sequence | Hours | Credits (Units) | |
| With Teacher | Independent | ||||
| RESEARCH SEMINAR I * | DBM6041 |
PTA5011 DBM5131 DBM5171 |
48 | 48 | 6 |
| THESIS III * | DBM6091 |
PTA5011 DBM5131 DBM5171 |
48 | 48 | 6 |
| 96 | 96 | 12 | |||
*Para cursar la asignatura RESEARCH SEMINAR I (Clave: DBM6041) es necesario haber acreditado previamente
- PROFESSIONAL RESPONSIBILITY SEMINAR
- PRE-DOCTORAL EXAM
- THESIS II
*Para cursar la asignatura THESIS III (Clave: DBM6091) es necesario haber acreditado previamente
- PROFESSIONAL RESPONSIBILITY SEMINAR
- PRE-DOCTORAL EXAM
- THESIS II
Molecular BiomedicineSeventh Term |
|||||
|---|---|---|---|---|---|
| Course List | Code | Sequence | Hours | Credits (Units) | |
| With Teacher | Independent | ||||
| RESEARCH SEMINAR II * | DBM6051 |
DBM6041 |
48 | 48 | 6 |
| THESIS IV * | DBM6101 |
DBM6091 |
48 | 48 | 6 |
| 96 | 96 | 12 | |||
*Para cursar la asignatura RESEARCH SEMINAR II (Clave: DBM6051) es necesario haber acreditado previamente
- RESEARCH SEMINAR I
*Para cursar la asignatura THESIS IV (Clave: DBM6101) es necesario haber acreditado previamente
- THESIS III
Molecular BiomedicineEighth Term |
|||||
|---|---|---|---|---|---|
| Course List | Code | Sequence | Hours | Credits (Units) | |
| With Teacher | Independent | ||||
| RESEARCH SEMINAR III * | DBM6061 |
DBM6051 |
48 | 48 | 6 |
| THESIS V * | DBM6111 |
DBM6101 |
48 | 48 | 6 |
| 96 | 96 | 12 | |||
*Para cursar la asignatura RESEARCH SEMINAR III (Clave: DBM6061) es necesario haber acreditado previamente
- RESEARCH SEMINAR II
*Para cursar la asignatura THESIS V (Clave: DBM6111) es necesario haber acreditado previamente
- THESIS IV
Molecular BiomedicineNinth Term |
|||||
|---|---|---|---|---|---|
| Course List | Code | Sequence | Hours | Credits (Units) | |
| With Teacher | Independent | ||||
| RESEARCH SEMINAR IV * | DBM6071 |
DBM6061 |
48 | 48 | 6 |
| THESIS VI * | DBM6121 |
DBM6111 |
48 | 48 | 6 |
| 96 | 96 | 12 | |||
*Para cursar la asignatura RESEARCH SEMINAR IV (Clave: DBM6071) es necesario haber acreditado previamente
- RESEARCH SEMINAR III
*Para cursar la asignatura THESIS VI (Clave: DBM6121) es necesario haber acreditado previamente
- THESIS V
Molecular BiomedicineTenth Term |
|||||
|---|---|---|---|---|---|
| Course List | Code | Sequence | Hours | Credits (Units) | |
| With Teacher | Independent | ||||
| RESEARCH SEMINAR V * | DBM6081 |
DBM6071 |
48 | 48 | 6 |
| THESIS VII * | DBM6131 |
DBM6121 |
48 | 48 | 6 |
| 1248 | 1232 | 155 | |||
*Para cursar la asignatura RESEARCH SEMINAR V (Clave: DBM6081) es necesario haber acreditado previamente
- RESEARCH SEMINAR IV
*Para cursar la asignatura THESIS VII (Clave: DBM6131) es necesario haber acreditado previamente
- THESIS VI
BE A UDLAP STUDENT
DOWNLOAD THE BROCHURE TO RECEIVE MORE INFORMATION
ACCREDITATIONS

Know the doctoral degree program
Train doctors in Molecular Biomedicine, able to design and develop collaborative and cutting-edge research integrating different disciplines of the medical, biological and chemical areas with complementary approaches, as well as mastering molecular biomedicine technologies, techniques and laboratory equipment in Biomedical research through the development of biological, biotechnological and chemical products to solve health problems, enhance research in biomedicine and contribute to life quality.
Likewise, the program seeks to form specialists capable of promoting and effectively communicate the results of their research in scientific media that represent, through a scientific contribution, an advance in knowledge within the biomedical field.
The candidate who enters the postgraduate program (direct doctorate) requires a bachelor's degree in areas of health, biological sciences or an equivalent such as medicine, chemistry, biology, physics, pharmacy, health sciences, biotechnology, nanotechnology, among others. The average obtained in the degree program must be equal to or greater than 8 (scale 0 - 10). It does not contemplate aspiring with masters since it is a direct doctorate.
Knowledge
To enter, the candidate must pass an examination of general knowledge of the areas of study (chemistry, mathematics, biology, physiology, biochemistry) and demonstrate command of the English language. Know the fundamentals and management of chromatography, spectroscopy, ultraviolet, infrared, nuclear magnetic resonance and mass spectrometry equipment, as well as handle the fundamentals of molecular methods of analysis, different analytical chemistry techniques and it is desirable that the candidate has experience in research.
Abilities
- Capacity for observation, scientific analysis and common sense.
- Ability to adapt, learn and emotional stability.
- Ability to work in a team and in a multidisciplinary way.
- Ability to perform basic and clinical research.
- Ability to analyze problems.
- Ability to use different methods of analysis.
Attitudes
- Interest and motivation for the scientific development of science and technology.
- Availability to dedicate exclusively to their studies.
- Respect for life and ethical behavior.
- Sense of responsibility.
- Constancy, dedication and great desire for improvement.
- Concern for social, environmental and humanistic development.
Skills
- Ingenuity and creativity to develop research proposals.
- Self-criticism, sensitivity, and a capability for leadership.
- Clear Oral and in written communication of experimental results.
- Discern appropriate information for a topic (information literacy).
The graduate integrates the theoretical, methodological, practical and technical fundamentals of the discipline, acquired during the different subjects of the curriculum, to apply in his professional practice and to develop research in the biomedical area.
The knowledge, skills and abilities, attitudes and values that the graduate will develop are:
Knowledge
- Use laboratory techniques and equipment to obtain natural and synthetic compounds with biomedical application, by extracting or synthesizing new materials.
- To examine the data obtained in the development of experiments during the obtaining of natural and synthetic compounds using different techniques of substance analysis, for the treatment and analysis of the results of the investigation.
- Synthesize the results of research in technical reports, review articles and posters, using the appropriate formats to disseminate new knowledge.
- Analyze results of the development of biomedical products and processes using statistical methods in experiments to generate continuous improvement and ensure effectiveness and reproducibility of research results.
- Analyze and integrate efficiently and effectively the results of their research to present them through the writing of articles in specialized scientific journals and outreach, oral presentations in seminars and active participation in national and international congresses and symposia.
- Develop and defend clear, adequate and efficient research proposals, in obtaining the necessary funds to carry out quality research, participating in the calls for national and international organizations in molecular biomedicine.
Skills and abilities
- Design original proposals for interdisciplinary research in biological health sciences and chemistry, applied to biomedical problems, which contribute to the generation of original scientific knowledge in their area and which are based on the highest ethical principles.
- Develop and conduct projects in the resolution of biomedical problems applying fundamentals of the different areas of molecular biomedicine, to generate border knowledge.
- Participate in collaborative interdisciplinary working groups for the development of research projects.
- To implement technological alternatives in the development of biomedical products for the diagnosis and treatment of pathologies through systematic methodologies specific to the area of molecular biomedicine.
- It participates competitively in the various sectors of academia, government or industry through its participation in national and international calls to promote research programs in biomedicine.
Attitudes
- It commits itself to its continuous professional development, through its participation in different academic forums of its discipline, to stay updated in the biomedical area and to exercise its profession with efficiency and responsibility.
- It is committed to the training of high level human resources as a transmitter of knowledge in theoretical and / or experimental teaching, with the purpose of contributing to the advancement of science.
- It shows availability and flexibility when working as a team, being tolerant to different personal and professional points of view, to achieve a harmonious and productive collaborative work.
- It proposes sustainable solutions through the application of methods and techniques that do not affect the environment and its community.
- It undertakes to carry out research in favor of the human being by applying the ethical standards of biomedicine to contribute to raising the quality of life of the population.
Values
- Respect the ethical principles in the exercise of your profession for the benefit of all living beings.
- Propose strategies that demonstrate a social commitment for the benefit of society.
- Natural and synthetic compounds with biomedical applications: In this line we investigate new pharmacological actives, the synthesis, purification, characterization and evaluation of organic and inorganic compounds, including nanomaterials, whose biological activity has potential biomedical applications, emphasizing the specific interaction that these compounds can have with different biomolecules, in order to elucidate the mechanisms of biological activity.
- Preclinical research on biotechnology and therapeutics: In this line several techniques associated with the field of translational research are used to find new treatments and diagnoses, including the evaluation of the viability of new chemical and biotechnological products through the design of preclinical studies.
Other topics of interest
Note: Offering of the program is subject to the number of students enrolled.
Faculty.
The study program consists of 155 credits distributed in 28 subjects and is covered in 10 periods. To pass the credits of each subject, the student must obtain a minimum passing grade of 8.0 on a scale of 0 to 10.0 as indicated in the student manual.
The program is designed in such a way that once students complete the first 11 courses in four periods, a seminar, and a pre-doctoral project, they will be evaluated by the program's professors to allow them to continue their doctoral studies.
Escolar
DIPES: RVOE 20220655; AUTORIZADO DGAIR/DIPES/SR/DC/04307/2022
Graduates
*Encuesta del estudio de ocupación generación 77.
Lear more
Contact us
Dirección General de Doctorados
Tel.: +52 (222) 229 20 00 ext. 2725 y 6005
informes.doctorados@udlap.mx